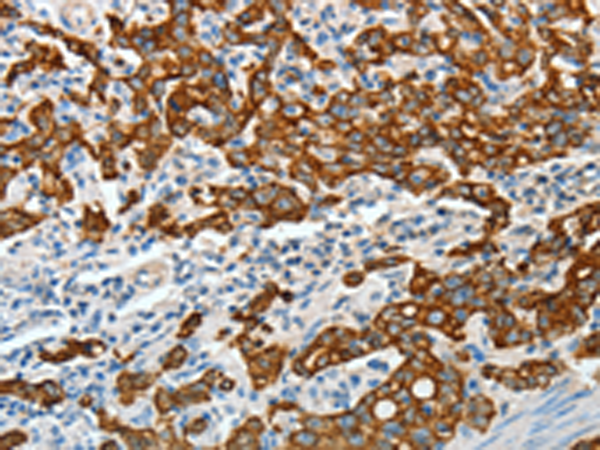

技術規格
Background:
KRT18 encodes the type I intermediate filament chain keratin 18. Keratin 18, together with its filament partner keratin 8, are perhaps the most commonly found members of the intermediate filament gene family. They are expressed in single layer epithelial tissues of the body. Mutations in this gene have been linked to cryptogenic cirrhosis. Two transcript variants encoding the same protein have been found for this gene.
Applications:
ELISA, WB, IHC
Name of antibody:
KRT18
Immunogen:
Fusion protein of human KRT18
Full name:
keratin 18, type I
Synonyms:
K18; CYK18
SwissProt:
P05783
ELISA Recommended dilution:
1000-2000
IHC positive control:
Human gastric cancer and human colon cancer
IHC Recommend dilution:
50-200
WB Predicted band size:
48 kDa
WB Positive control:
K562 cell
WB Recommended dilution:
200-1000

購物車
幫助
021-54845833/15800441009
